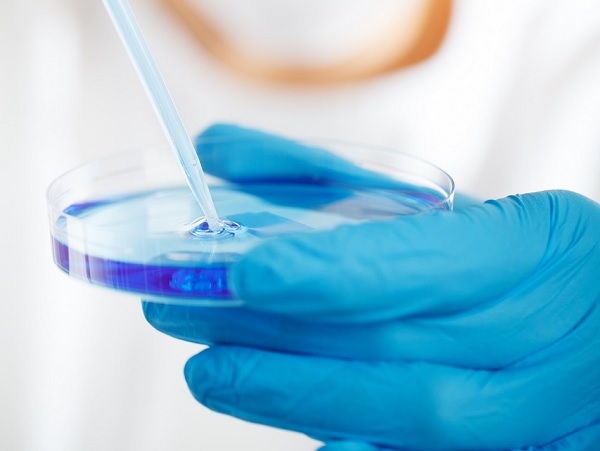
Последните 20 30 години онкологията е в своя възход и целта

... Едуард М. Кенеди. Той също така ще оглави събитие за Демократическата партия на Небраска в Омаха следващия месец. Вижте всички теми Връзката е копирана! Следвайте
Терапия Лечение - Новини
Бившият президент Джо Байдън завърши кръг от лъчева терапия за
...... нашия талант Общност Помощ Обратна връзка Свържете се с омбудсманаАвторско право ©2025 CBS Interactive Inc. Всички права запазени.Вижте CBS News В приложението CBS News OpenChromeSafariПродължете
Германия ще стане първата страна в ЕС която ще позволи
...... се пълното одобрение в Германия да отнеме още няколко години, но схемата за състрадателна употреба ще даде шанс на пациенти, които „не могат да чакат“.
Добре знаем колко важен е приемът на достатъчно вода за
...... пием, толкова по-малко задържаме в организма. Пиенето на вода преди хранене и ограничаването на неговото време също може да доведе до приемането на по-малко калории.
сезон 2 на риалити шоуто Тайният живот на съпругите на
...... опасни странични ефекти, той каза. Асистент с Fox News Digital. Тя и екипът на Lifestyle обхващат редица истории, включително храна и напитки, пътувания и здраве.
девет и половина от месец KJ Muldoon от Clifton Heights
...... този, няма да отнеме време", за да се включат други отбори в Университета в Маями, който не е включен в проучването. Пет до 10 години.
Комитетът по лекарствените продукти за употреба в хуманната медицина CHMP
...... на препарата ще бъде публикувана в официалния вестник на ЕС след като ЕК издаде разрешение за употребата му в страните от общността, уточняват от ЕMA.
След като Шон Диди Комбс беше арестуван по обвинение в
...... }}, {"__ typename": "link", "displayTitle": "Royal Семейство "," справка ": {" __ typename ":" категория "," uri ({ "издание ": "us "}) ":" u002fnews u
Вдишваш казваш си Спокоен съм издишваш Направете четири такива обръча
...... се върне с втори семинар през януари. Идеята й е с времето да обучи инструктори, които да прилагат нейния метод у нас. Източник: Уикенд
Нова радиоактивна терапия е намалила наполовина смъртоносния мозъчен тумор на
...... изследователите планират да комбинират ATT001 с имунотерапия - която обучава имунната система на организма да унищожава раковите клетки. Не пропускайте най-важните новини - последвайте ни в
Последните 20 30 години онкологията е в своя възход и целта
...... той.Експертите обаче уточниха, че засега онколитичната терапия може да се прилага само локално - при директно инжектиране в тумора. Целия епизод на подкаста може да чуете
Според проучване на китайски изследователи бактериална терапия предлага обещаващ нов
...... пробиотици със силен антиоксидантен капацитет и силно регулаторно въздействие върху чревната флора, като предостави нови познания за превенцията и инхибирането на колоректалния рак“, казва Ли.
Учени от Китай съобщиха за успешното провеждане на експерименталното лечение
...... момента учените се подготвят да проведат клинични изпитвания с голяма извадка от пациенти, за да потвърдят ефективността и безопасността на клетъчната терапия за всички хора.
Китайски учени разработиха нова терапия за лечение на наранявания при
...... регенерацията. Изследването представлява нова концепция за имуномодулатор и интегрирана регенерация на сухожилията и другите околни тъкани, обяви екипът, провел изследването. Резултатите са публикувано в сп. "Сайънс адвансис".
Вчера беше Тодоровден ден в който конете са на почит Цвети
...... Благодаря им за това, което ни дават, и Тодоров ден те ще прекарат пуснати на поляните - един щастлив и спокоен ден“, коментира Веселина Фелдман.
Вчера беше Тодоровден ден в който конете са на почит Цвети
...... Благодаря им за това, което ни дават, и Тодоров ден те ще прекарат пуснати на поляните - един щастлив и спокоен ден“, коментира Веселина Фелдман.
Сценарист който е работил по шоуто на Розан Бар твърди
...... се изкачваше към публиката, така че хората да я гледат там и да остави Естел да има момент да се събере, погледнете сценария“, добави той.
Бивш член на персонала на крал Чарлз сподели подробности за
...... помогнат да се справите по-добре със симптомите, причинени от рака. Или страничните ефекти, причинени от лечението на рак." Имате ли история за разказване? Имейл: [email protected]
Лили Райнхарт сподели видеоклип на това че се подлага на
...... помощ и подкрепа в Обединеното кралство се свържете със Samaritans на 116 123.В САЩ се свържете с Lifeline чрез обаждане или текстово съобщение на 988
Американски специалисти прилагат експериментално обещаваща процедура за лечение на тежки
...... Калифорния. Обичам летенето", казва той. Младят мъж е много благодарен, че е получил възможност да се включи в експерименталната терапия, "защото това наистина ми помогна."
Учените имаха обещаващи резултати в предварителния етап на изпитване за
...... само начална стъпка в пътуването към клинично приложение. За да се установи безопасността, ефикасността и по-широката приложимост на този новаторски подход, са необходими допълнителни изследвания.
Британският регулаторен орган по лекарствата разреши първото в света лечение
...... на живоПравила за поверителност на ABC News Network Вашите права за поверителност на щат САЩ Правила за поверителност онлайн на децата Реклами, базирани на интереси
Новата терапия на рак използваща антитяло може да предложи по малко
...... терапия на рак, използваща антитяло, може да предложи по-малко токсична възможност за лечение - Авторски права Canva От Oceane Duboust Публикувано на 31/10/2023 - 14:45 Споделете тази статияFacebookTwitter
Съществуват различни видове лечения разглеждащи връзката между човека и света
...... подпомагане на здравословен начин на живот и укрепване на имунната система, холистичното лечение може да помогне за предотвратяване на различни заболявания и насърчаване на дълголетието.
Горилата от зоологическата градина в Будапеща на име Лизел е
...... преди това са били подложени на подобна терапия със стволови клетки. Учените разработват подобно лечение за хора, но изследванията все още са в много ранен етап.
Съвременните лекарства за лечение на криптококов менингит са токсични и
...... лекарство може да бъде важна част от лечението на пациентите“, казва съавторът на разработката Махса Абаси. Клиничната фаза на оценката на лекарството все още продължава.
Evox Therapeutics компания за екзозомна терапия обяви споразумение за сътрудничество
...... Фужерол.„Ние вярваме, че можем да играем важна роля за напредъка на тези изследвания и по-бързото навлизане на тези нови подходи в клиничната практика“, заключи той.
По последни данни всяка година в България се диагностицират над
...... в Париж. Учен, преподавател, автор на научни публикации, съавтор в 3 монографии и 2 учебника по вътрешни болести. BGR-NP-0223-80009 Материалът се публикува с подкрепата на Амджен България
Датското разузнаване смята че Путин е дал заповед за започване
...... казва Йоаким. Разузнавачът не назова източниците на информацията си, но увери, че не става въпрос само за изучаване на видеозаписи с участието на руския президент.
Комитетът по лекарствените продукти в хуманна медицина CHMP към Европейската
...... което се дължи на нарушение на кръвосъсирването, причинено от липса на фактор VIII.Roctavian също получи зелена светлина чрез схемата на EMA за приоритетни лекарства PRIME.
Американската агенция по храните и лекарствата FDA одобри терапия базирана
...... на терапията.Освен Ferring и други фармакомпании проявяват интерес към разработването на такива продукти. Seres Therapeutics вече работи над създаването на орално лечение с фекална микробиота.
Националната здравна служба на Великобритания NHS обяви плановете си да
...... традиционните терапевтични подходи за контрол на пристъпите. LITT ще даде на хората с неповлияваща се до този момент епилепсия реален шанс да живеят нормален живот“.
Настояваме здравните власти да положат усилия върху адекватното лечение при
...... попадат в рискова група като възрастните, тези с хронични заболявания и имунодефицитни състояния, трябва да полагат необходимите мерки за своето предпазване и ограничаване на контактите.
На последното си заседание Комитетът по лекарствата в хуманната медицина
...... всеки момент са на разположение за овладяване на реакции, свързани с инфузията.Очаква се ЕК да издаде разрешение за употреба на продукта в страните от ЕС.
Обучение на тема 40 години от обявяване на ХИВ пандемията
...... с неоткриваем вирусен товар не заразяват по полов път, тоест рязко намалява трансмисията на този вирус.” , заяви проф. д-р Мариана Стойчева, специалист по инфекциозни болести.
Амиотрофичната латерална склероза е невродегенеративно заболяване с генетичен произход което
...... проучвания при засегнати пациенти.Източници:www.inserm.fr Материалът има информативен характер и не може да замести консултацията с лекар. Преди да предприемете лечение, задължително се консултирайте с лекар.
Не всяко възпаление на зъб се нуждае от ендодонтска терапия
...... други подобни). Консултирайте се с вашия , за да определите коя ендодонтска процедура е оптимална за вас и коя терапия може да даде най-добрите резултати. *публикация
Европейската комисия одобри за употреба в Европейския съюз ново лекарство
...... тежка форма. След одобрението от Европейската комисия предстоят редица административни процедури, за да започне медикаментът да се заплаща и в България от Националната здравноосигурителна каса.
Учени от Българската академия на науките БАН тестват иновативна терапия
...... борба с инфекциозни, невродегенеративни и злокачествени заболявания и да подобри качеството на живот на населението чрез естествени продукти в сферите на персонализираната и превантивна медицина.
Ръководител на проекта е докторант Мария Шрьодер завърнала се от
...... вещество е дълъг и труден процес, пълен с неизвестни, но мисълта на колко хора може да помогне е движещата сила за мен“, коментира Мария Шрьодер.
Талантливият но много проблематичен холивудски актьор Шая Лабьоф достигна повратна
...... терапия за управление на гнева. Самият актьор многократно е заявявал публично, че алкохолът е основният виновник за всички неприятности, които е имал в предходните години.
Психолозите в Албания забраниха така наречената конверсивна терапия с която
...... осъди практиката и призова страните членки да я забранят.По-рано този месец Германия стана втората европейска държава след Малта, която забрани конверсивната терапия при непълнолетни. /news.bg
Министърът на здравеопазването на Германия е уверен че скоро ще
...... на хора чрез репаративна терапия. Някои опити се правят от членове на семейството, треньор, терапевти, понякога се използват молитви и дори се стига до екзорсизъм.
Комисия ще разрешава лечение с лекарства които са засегнати от
...... на здравеопазването няма да бъдат лишени от средства“, добави още Ананиев. Той допълни, че правителството ще даде подкрепата си, ако са необходими допълнително пари.
Гергана Ламбрева е терапевт специалист по кранио сакрална терапия Oт ранна възраст
...... от всички възрасти и състояния на здравето. Как действа лечението и към кои проблемни зони е насочена терапията четете само на най-полезния здравен сайт zdrave.to

_8001685271699281835_small.jpg)



